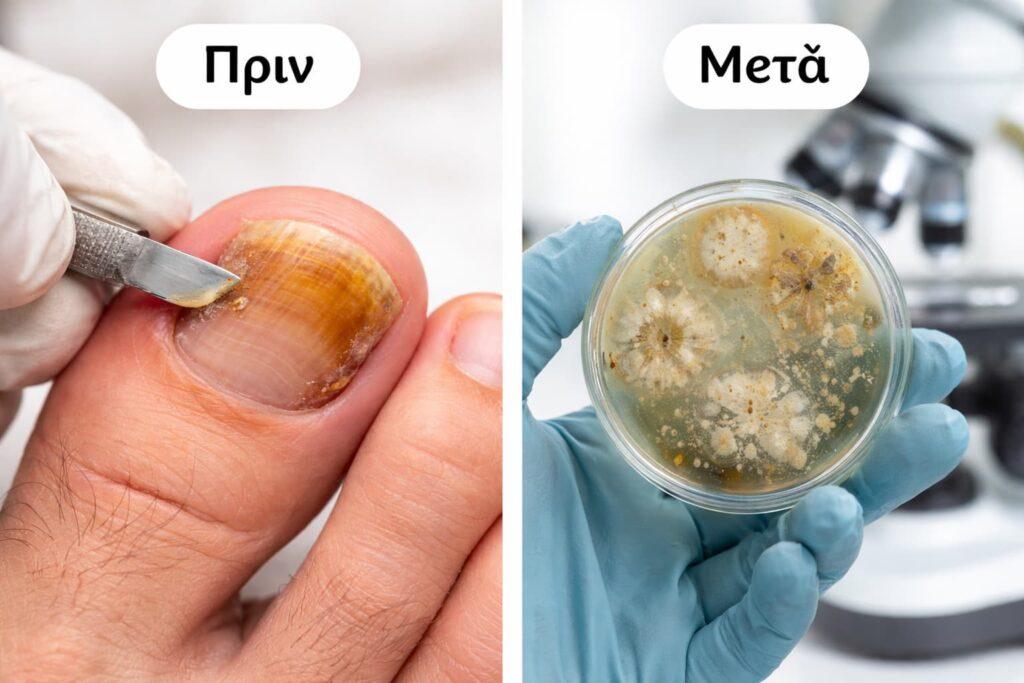
Λήψη δείγματος νυχιού για διάγνωση ονυχομυκητίασης

Ονυχομυκητίαση: Πώς φαίνεται, πώς επιβεβαιώνεται και πώς αντιμετωπίζεται
Ενημερώθηκε: 8/4/2026
Το περιεχόμενο είναι ενημερωτικό και δεν υποκαθιστά ιατρική εκτίμηση, διάγνωση ή θεραπεία. Για αλλαγές στο χρώμα, στο πάχος ή στο σχήμα των νυχιών χρειάζεται αξιολόγηση από δερματολόγο.
Η ονυχομυκητίαση είναι μυκητιασική λοίμωξη του νυχιού που μπορεί να προκαλέσει κιτρίνισμα ή καφέ χρώμα, πάχυνση, θρυμματισμό και αποκόλληση. Δεν είναι όμως κάθε αλλοίωση στο νύχι μύκητας. Η σωστή διάγνωση από δερματολόγο, και όπου χρειάζεται εργαστηριακή επιβεβαίωση, βοηθούν να επιλεγεί η κατάλληλη θεραπεία.
Τι είναι η ονυχομυκητίαση;
Η ονυχομυκητίαση είναι λοίμωξη του νυχιού από μύκητες και εμφανίζεται συχνότερα στα νύχια των ποδιών, αν και μπορεί να επηρεάσει και τα νύχια των χεριών. Συνήθως δεν είναι επικίνδυνη, αλλά δεν είναι πάντα μόνο αισθητικό ζήτημα, γιατί σε ορισμένες περιπτώσεις μπορεί να προκαλεί ενόχληση, πόνο ή δυσκολία στη βάδιση και στη φροντίδα των νυχιών.
Πώς φαίνονται οι μύκητες στα νύχια;
Είναι κάθε αλλοίωση στο νύχι μύκητας;
Όχι. Η ονυχομυκητίαση ευθύνεται περίπου για το μισό των δυστροφιών των νυχιών, άρα πολλές αλλοιώσεις σχετίζονται με άλλα αίτια, όπως τραυματισμό, ψωρίαση, δερματίτιδα ή άλλες παθήσεις του νυχιού. Αυτός είναι και ο λόγος που η αυτοδιάγνωση συχνά οδηγεί σε άσκοπη ή λάθος θεραπεία.
Χρήσιμη διάκριση: ένα νύχι που άλλαξε μετά από χτύπημα, στενά παπούτσια ή επαναλαμβανόμενο μανικιούρ μπορεί να μοιάζει με μύκητα χωρίς να είναι.
Ποιοι έχουν αυξημένο κίνδυνο για ονυχομυκητίαση;
Ο κίνδυνος αυξάνεται με την ηλικία και είναι μεγαλύτερος όταν συνυπάρχουν κλειστά παπούτσια, έντονη εφίδρωση, τραυματισμοί του νυχιού, μυκητίαση δέρματος στα πόδια (athlete’s foot / tinea pedis), σακχαρώδης διαβήτης ή προβλήματα στην κυκλοφορία. Η ονυχομυκητίαση είναι πολύ λιγότερο συχνή στα παιδιά.
Πώς γίνεται η διάγνωση;
Η διάγνωση ξεκινά με ιστορικό και κλινική εξέταση. Όταν η εικόνα δεν είναι απολύτως σαφής ή όταν σχεδιάζεται από του στόματος θεραπεία, ο γιατρός μπορεί να ζητήσει εργαστηριακή επιβεβαίωση από δείγμα νυχιού. Η βιβλιογραφία υποστηρίζει ότι η επιβεβαίωση της λοίμωξης πριν από θεραπεία βοηθά να αποφευχθούν λάθος αγωγές, ειδικά στις περιπτώσεις όπου το νύχι μοιάζει με μύκητα αλλά δεν είναι.
Πριν από θεραπεία για μύκητες νυχιών, συχνά χρειάζεται επιβεβαίωση της διάγνωσης με εξέταση δείγματος νυχιού.
Ποια θεραπεία ταιριάζει σε κάθε περίπτωση;

Η από του στόματος θεραπεία είναι γενικά πιο αποτελεσματική, αλλά δεν ταιριάζει σε όλους. Χρειάζεται έλεγχος αντενδείξεων, πιθανών αλληλεπιδράσεων και σωστή ιατρική επιλογή. Οι τοπικές θεραπείες έχουν λιγότερες αλληλεπιδράσεις, αλλά θέλουν συνέπεια και μεγάλο χρονικό διάστημα εφαρμογής.
Βοηθά το laser στους μύκητες νυχιών;
Το laser είναι επιλογή που μπορεί να συζητηθεί σε ορισμένες περιπτώσεις, αλλά δεν πρέπει να παρουσιάζεται ως εγγυημένη ή βασική λύση για όλους. Η American Academy of Dermatology αναφέρει ότι τα lasers δεν είναι FDA-approved για θεραπεία της λοίμωξης του νυχιού και ότι χρειάζονται καλύτερα σχεδιασμένες μελέτες για να ξεκαθαρίσει η πραγματική τους αποτελεσματικότητα.
Σημαντικό: το σωστό framing δεν είναι “laser αντί για όλα τα άλλα”, αλλά “laser ως επιλεγμένη ή συμπληρωματική επιλογή, ανάλογα με την περίπτωση”.
Υπάρχουν φυσικές λύσεις;
Πολλοί ασθενείς δοκιμάζουν μόνοι τους ξύδι, χλωρίνη, ιώδιο ή άλλα διαλύματα, αλλά αυτό μπορεί να ερεθίσει το δέρμα και να επιβαρύνει το νύχι χωρίς να λύνει τη λοίμωξη. Για ορισμένες ουσίες υπάρχουν περιορισμένα δεδομένα ή μικρές μελέτες, αλλά αυτό δεν σημαίνει ότι αποτελούν ισοδύναμη ή αποδεδειγμένη θεραπεία.
Ουσίες όπως χλωρίνη, οξυζενέ ή ερεθιστικά διαλύματα δεν πρέπει να εφαρμόζονται στο νύχι χωρίς ιατρική οδηγία, γιατί μπορεί να προκαλέσουν ερεθισμό ή επιπλέον βλάβη.
Πόσο χρόνο θέλει η βελτίωση;
Η βελτίωση είναι αργή, ακόμη και όταν η θεραπεία λειτουργεί σωστά. Το νύχι χρειάζεται χρόνο για να ξαναβγεί, γι’ αυτό η εικόνα δεν αλλάζει γρήγορα. Τα νύχια των χεριών συνήθως βελτιώνονται πιο γρήγορα από των ποδιών, ενώ στα πόδια η πλήρης ανανέωση μπορεί να πάρει πολλούς μήνες.
Πώς μειώνεται ο κίνδυνος υποτροπής;
Η πρόληψη βασίζεται στη μείωση της υγρασίας και της επανέκθεσης. Βοηθούν τα καθαρά και στεγνά πόδια, η αλλαγή κάλτσας όταν ιδρώνει, τα παπούτσια που αναπνέουν, οι σαγιονάρες σε αποδυτήρια και πισίνες και η απολύμανση των εργαλείων περιποίησης. Αν υπάρχουν μύκητες ανάμεσα στα δάχτυλα, πρέπει να αντιμετωπίζονται επίσης, γιατί μπορούν να συντηρούν τον κύκλο της υποτροπής.
Πότε χρειάζεται ραντεβού με δερματολόγο;
Ιατρική αξιολόγηση χρειάζεται όταν η αλλοίωση επιμένει, επηρεάζει πολλά νύχια, προκαλεί πόνο, επιδεινώνεται ή συνυπάρχουν διαβήτης, ανοσοκαταστολή ή κυκλοφορικά προβλήματα. Το ίδιο ισχύει όταν σκέφτεσαι από του στόματος θεραπεία χωρίς να έχει προηγηθεί επιβεβαίωση της διάγνωσης.
Πηγές
- American Academy of Dermatology — Nail fungus: Diagnosis and treatment
- American Academy of Family Physicians — Onychomycosis: Rapid Evidence Review
- NHS — Fungal nail infection
- DermNet — Fungal Nail Infections
- American Academy of Dermatology — 11 tips to prevent nail fungus
Αν χρειάζεσαι αξιολόγηση για αλλαγές στα νύχια
Αν το νύχι έχει αλλάξει χρώμα, έχει παχύνει, σπάει ή ξεκολλά, η εξέταση από δερματολόγο βοηθά να ξεχωρίσουμε αν πρόκειται για ονυχομυκητίαση ή για άλλη πάθηση του νυχιού.
Το ιατρείο μας βρίσκεται στην Αθήνα, στη Λεωφόρο Βασιλέως Αλεξάνδρου 2 & Νηρηίδων, 11634, και μπορείτε να δείτε οδηγίες πρόσβασης ή να κλείσετε ραντεβού από τη σελίδα επικοινωνίας.
Οι πληροφορίες της σελίδας έχουν ενημερωτικό χαρακτήρα και δεν αντικαθιστούν εξατομικευμένη ιατρική συμβουλή. Αν το νύχι πονά, παχαίνει, αλλάζει χρώμα, ξεκολλά ή η εικόνα επιμένει, απευθυνθείτε σε δερματολόγο για σωστή διάγνωση.



